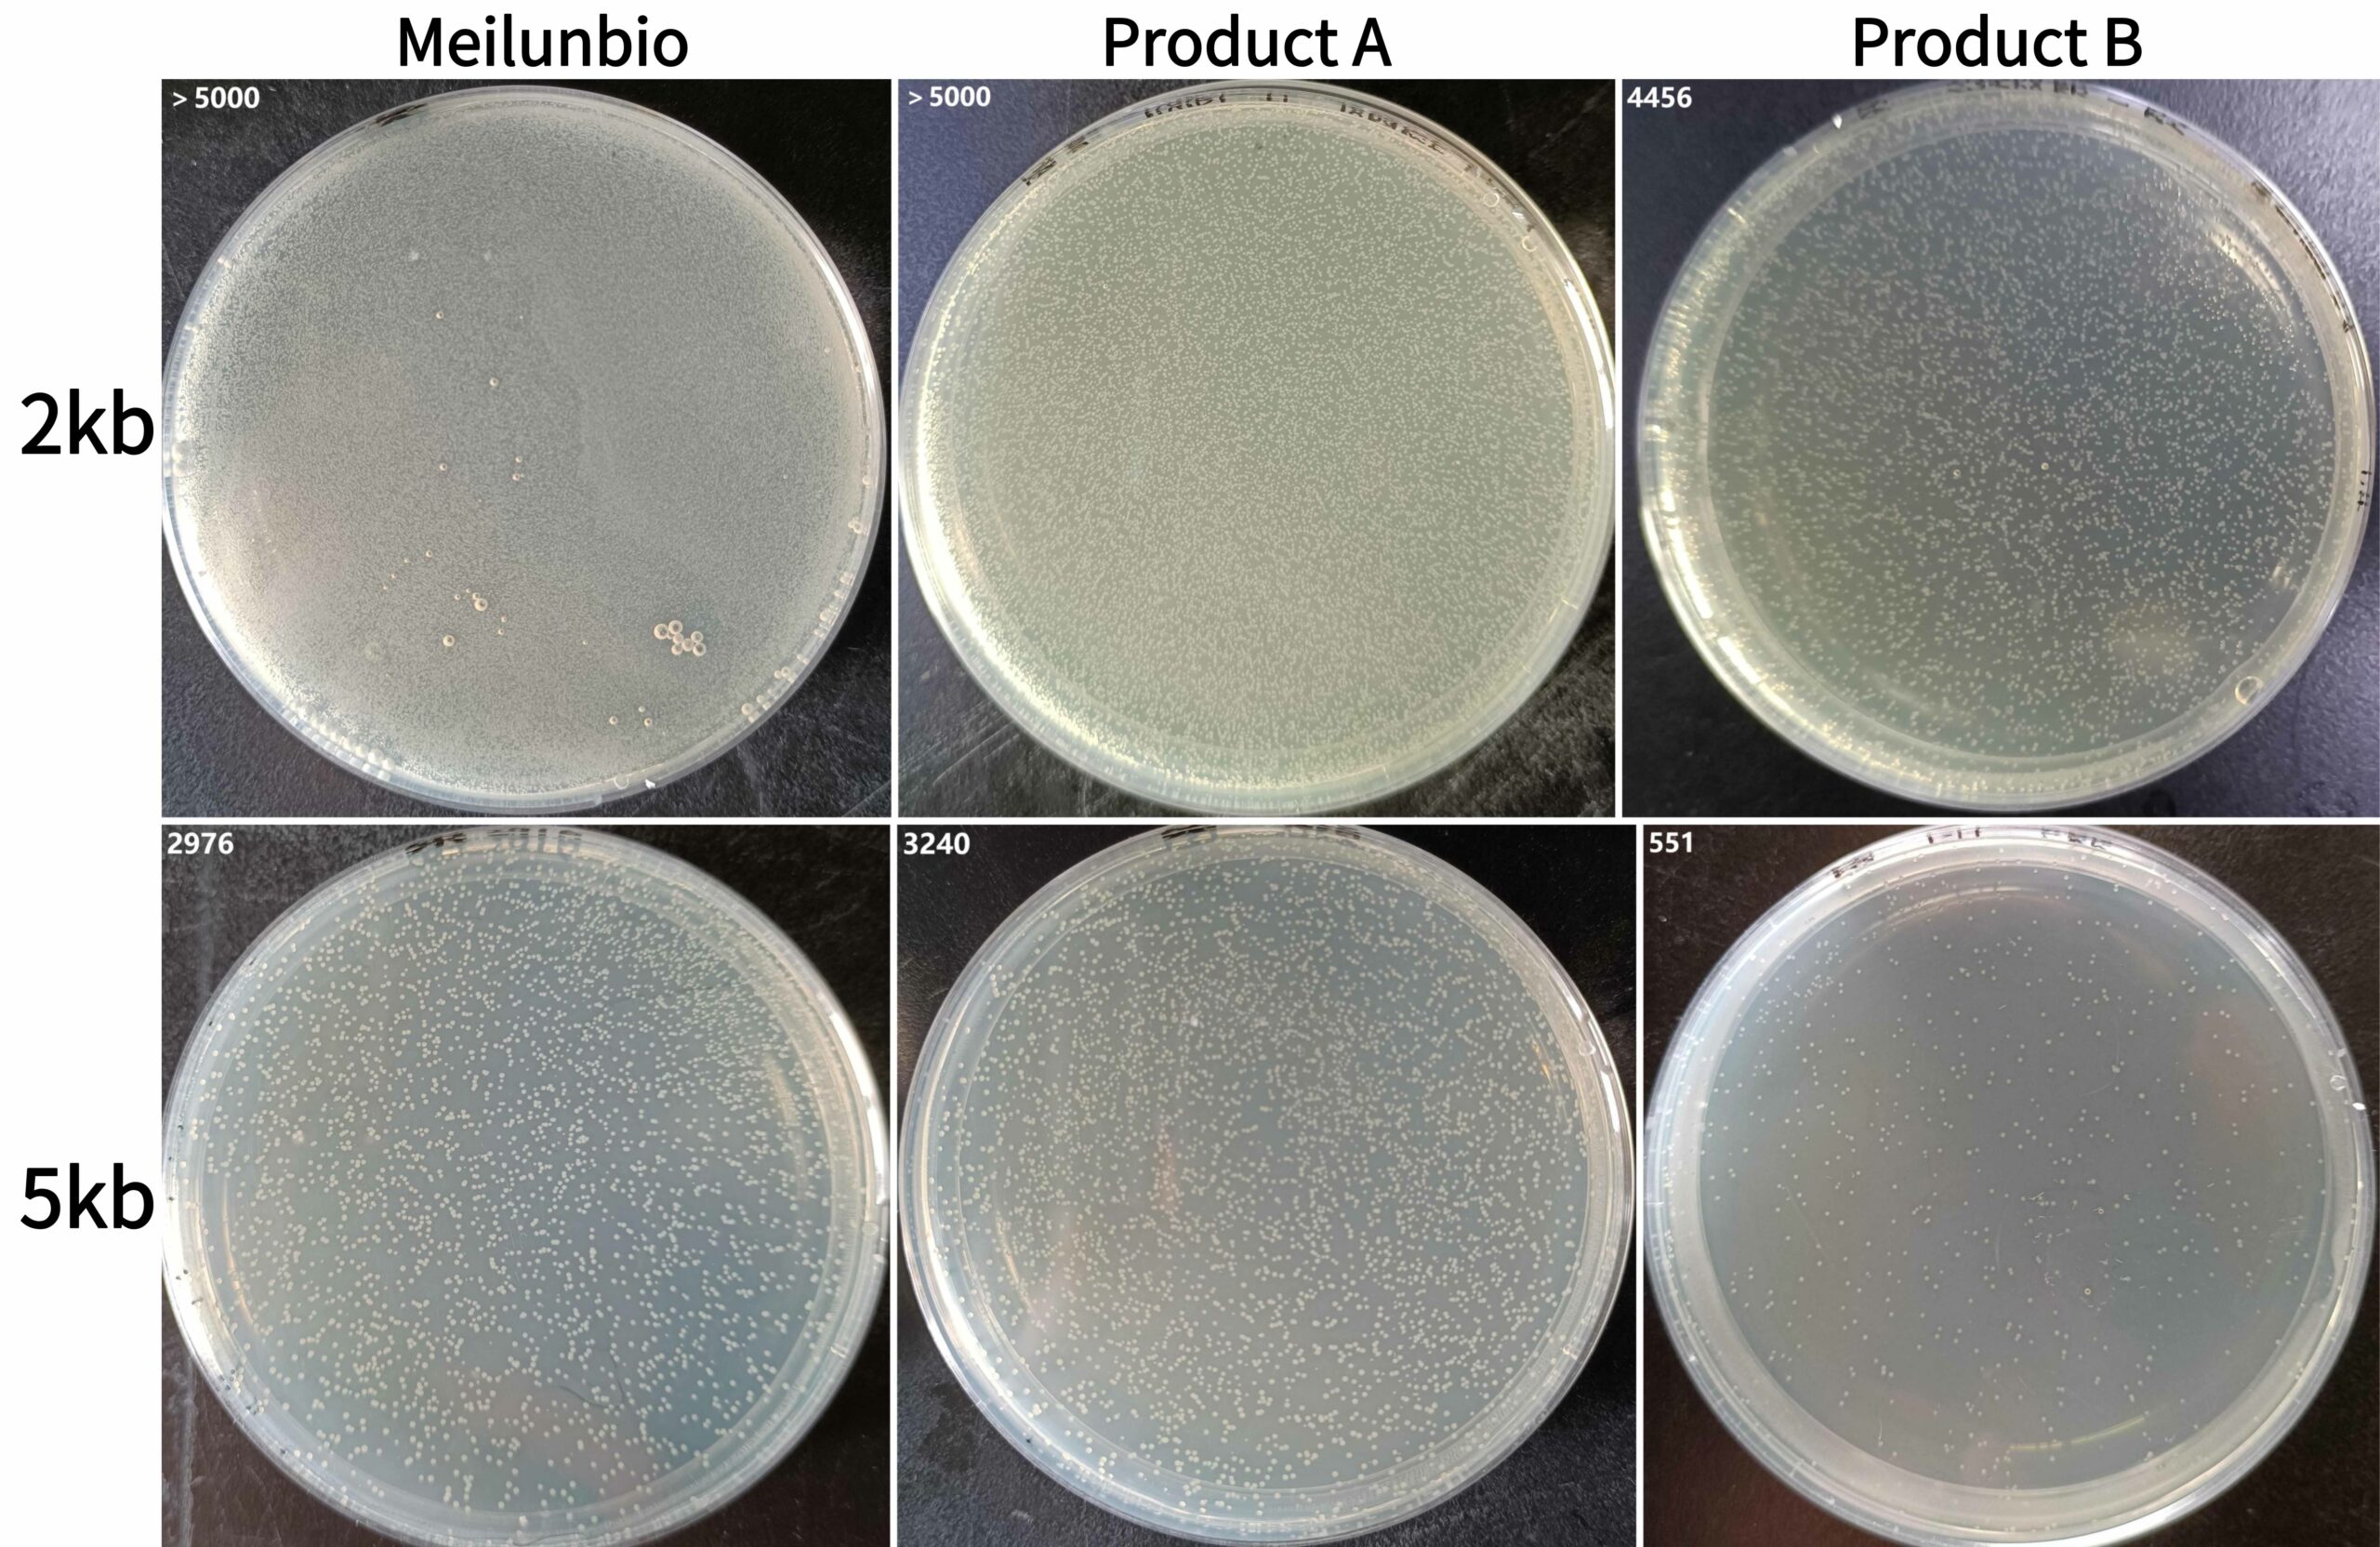
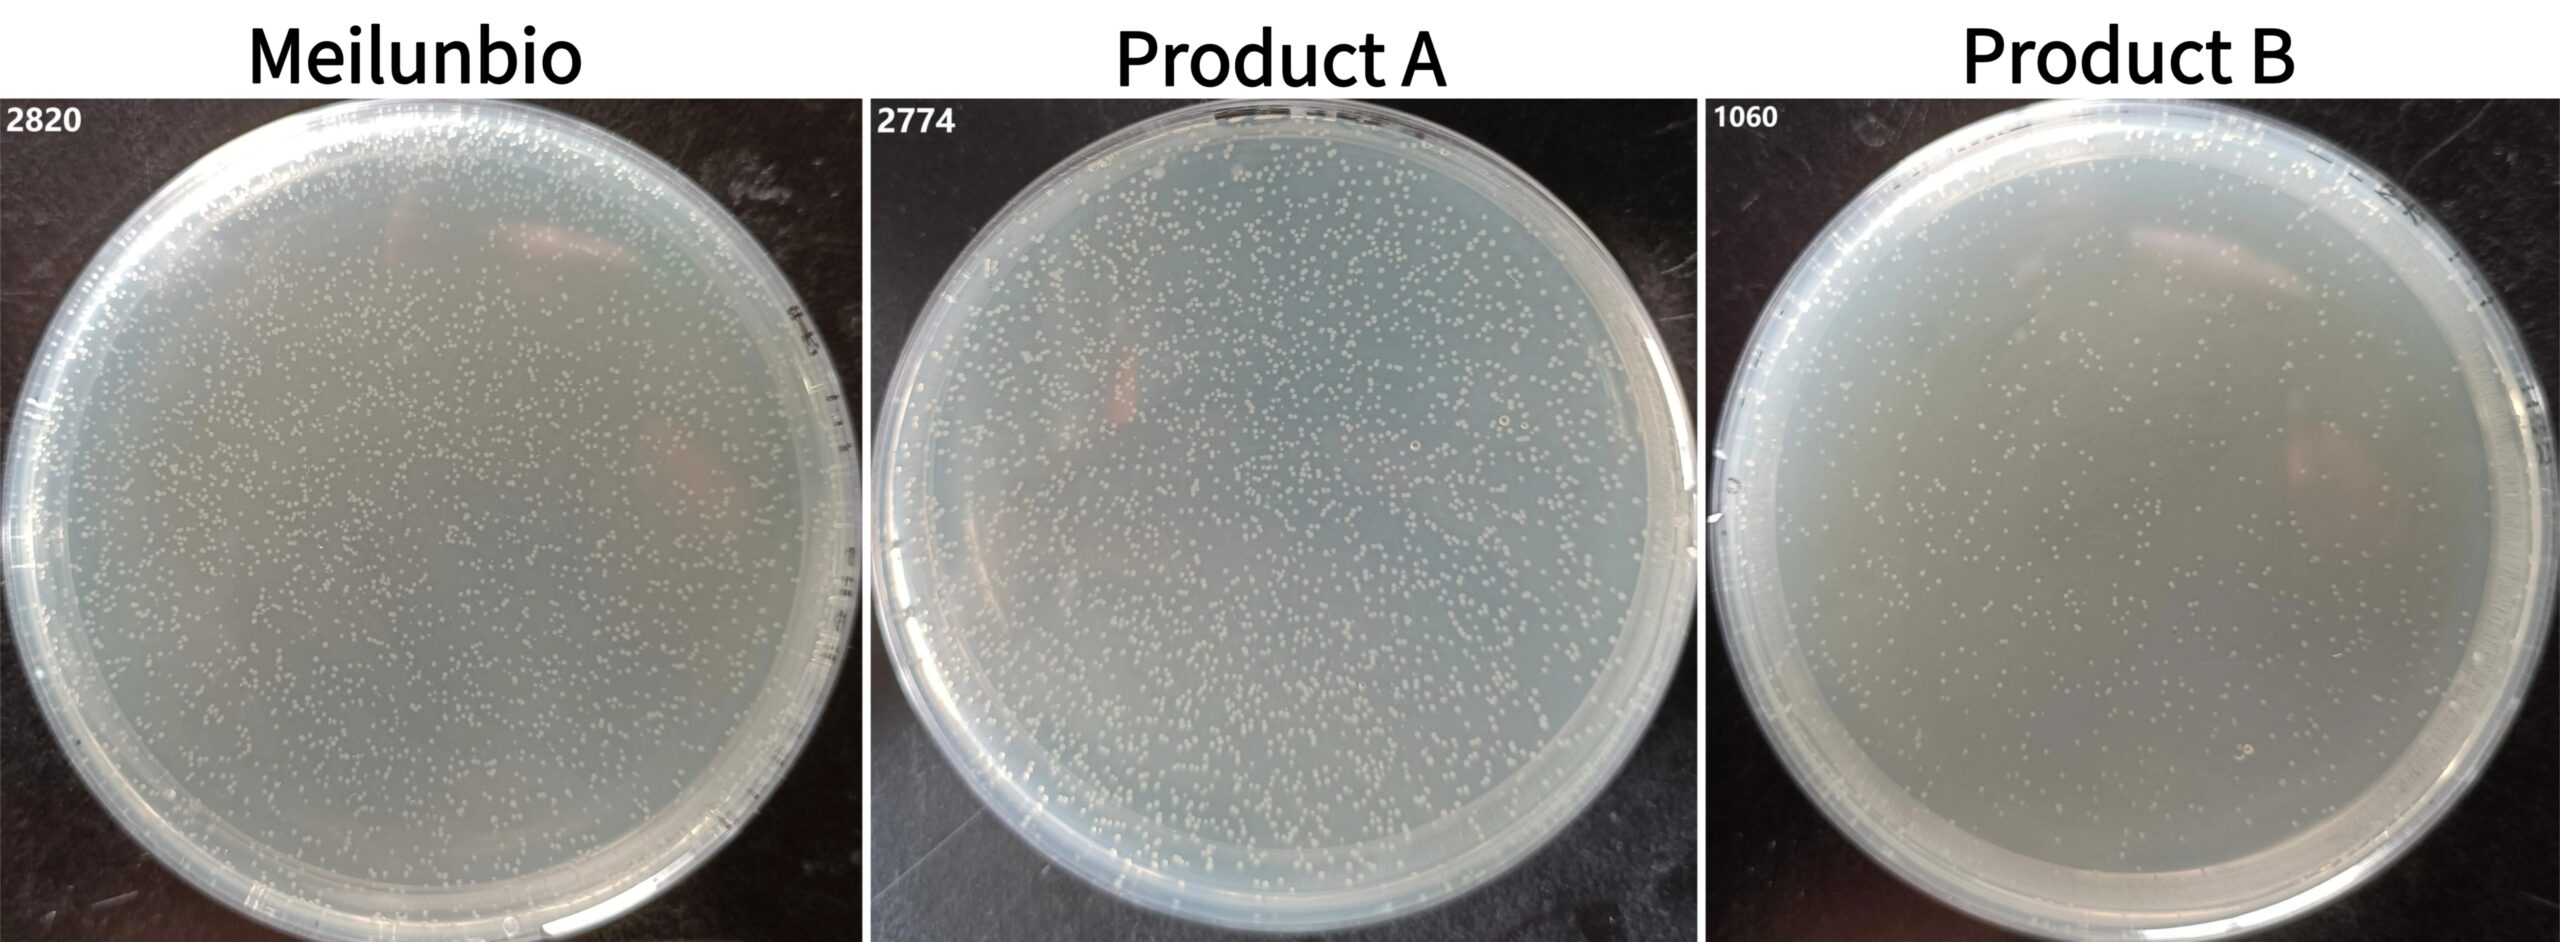
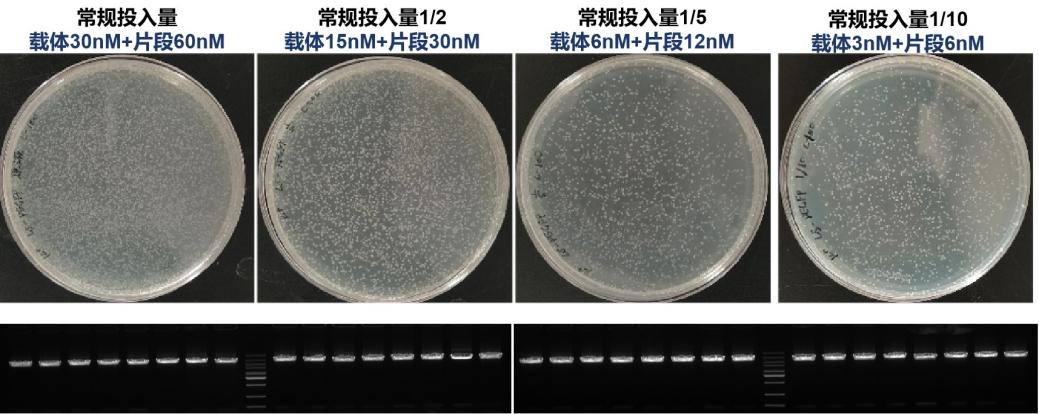

产品简介
One Step Seamless Cloning Kit(一步法无缝克隆试剂盒)是一款简单、快速、高效的DNA定向克隆试剂盒,该产品通过同源重组的方法可以将DNA片段重组至线性化载体上,不受酶切位点限制,载体自连背景极低。该方法的实现需要在插入片段正、反向PCR引物5’端引入15~25bp的线性化载体末端同源序列,使得插入片段PCR产物5’和3’末端分别带有与线性化载体两末端对应的完全一致的序列。具有重叠区域的片段和载体在重组酶的作用下,最快可在50℃反应5min,即可进行重组,完成无缝克隆。
本产品可同时实现1~5个DNA片段的重组,2×Seamless Cloning Mix中采用独特重组蛋白E-T,对DNA投入量的兼容性好,对于低浓度DNA片段重组效率高。
本产品适用于1~5个片段的快速无缝克隆、定点突变和高通量克隆等实验。
产品优势
- 快速:5~60min完成重组;
- 简单:本产品为2×预混液,操作简捷;不受酶切位点的限制,无需对片段酶切;
- 无缝:不引入额外序列;
- 高效:可对1~5个片段快速克隆重组,具有较高阳性率;
- 兼容:适用于单片段、多片段、入门克隆等多种实验。
数据展示
- 不同长度单片段重组效果比较
方法:分别使用One Step Seamless Cloning Kit及市售同类型产品Product A和Product B对2kb、5kb片段进行重组反应,重组产物转化到感受态DH5α中,观察菌落数及菌落PCR检测阳性率。
结果:如图1 和图2所示,MA2000的克隆数和阳性率均优于Product A和Product B。
图1. 单片段重组反应转化效果比较

图2. 单片段重组反应克隆阳性率比较
- 多片段重组效果比较
方法:分别使用One Step Seamless Cloning Kit及市售同类型产品Product A和Product B对3个片段进行重组反应,重组产物转化到感受态DH5α中,观察菌落数及菌落PCR检测阳性率。
结果:如图3和图4所示,MA2000的克隆数和阳性率均优于Product A和Product B。
图3. 三个片段重组反应转化效果比较
图4. 三个片段重组反应克隆阳性率比较
- 单片段低浓度样本重组效果比较
方法:使用One Step Seamless Cloning Kit分别对常规量和梯度低浓度样本进行重组反应,重组产物转化到感受态DH5α中,观察菌落数。
结果:如图5所示,MA2000在常规投入量1/10的极低投入量下依旧保持着高克隆成功率。
图5. One Step Seamless Cloning Kit对单片段低浓度样本重组效果比较
保存条件
-20℃保存,避免反复冻融,自生产之日起12个月有效。
运输条件
湿冰运输。
注意事项
1、本产品仅适用于科研领域,不适用于临床诊断或其他用途。
2、为了您的安全和健康,操作时请穿着实验服并佩戴一次性手套。
常见问题与解答
| 问题 | 可能原因 | 建议 |
| 平板上未长出克隆或克隆数目很少 | 操作原因 | 建议使用阳性对照,可排除试剂盒操作本身的影响,并进行进一步判定 |
| 引物设计不正确 | 引物包含15~25bp同源臂(不计算酶切位点),GC含量40%~60% | |
| 线性化载体与插入片段比例不佳 | 尽量按照说明书中推荐的量和比例配制重组反应体系 | |
| 载体和插入片段纯度低 | 未纯化DNA使用体积不应超过2μL(反应体系体积的1/5);建议线性化载体、PCR产物进行凝胶回收纯化,纯化产物溶解在ddH2O中 | |
| 感受态细胞效率低 | 自制感受态随着保存时间的增加,效率可能会降低,建议尽量使用新鲜感受态或高效的商业化感受态,确保其转化效率>107cfu/μg | |
| 多数克隆不含插入片段或含有不正确的插入片段 | PCR产物混有非特异扩增产物 | 优化PCR体系,提高特异性;胶回收PCR产物;鉴定更多的克隆 |
| 载体线性化不完全 | 可通过阴性对照检测载体是否线性化完全,优化酶切体系,提高限制性内切酶使用量、延长酶切反应时间、胶回收纯化酶切产物 | |
| 反应体系中混入了相同抗性的质粒 | PCR扩增模板为环状质粒时,如扩增产物未纯化直接用于重组反应时推荐Dpn I消化,或者对扩增产物进行胶回收纯化 | |
| 退火温度过低 | 尝试提高退火温度并设置退火温度梯度 | |
| 循环数过多 | 减少循环数至25~30 cycles | |
| 菌落PCR无条带或大小不对 | 引物不正确 | 推荐使用载体的通用引物进行菌检,或至少使用一条通用引物 |
| PCR体系或程序不合适 | 没有目的条带也没有空质粒条带,建议优化PCR体系、程序;或者提取质粒,以质粒做模板PCR验证;或者进行酶切验证 | |
| 重组失败 | 只有空质粒的条带,说明重组不成功,载体线性化不完全,建议优化酶切体系 |
相关产品
| MB2788 | 琼脂糖低电渗(Biogreen) | 100g |
| MA0682 | 2×Taq Master Mix (Dye Plus) | 1mL/5×1mL |
| MA2001 | 1.1×Hi-Fidelity PCR Master Mix (Dye Plus) | 1.125mL/5×1.125mL |
| MA0007 | 质粒小提试剂盒 | 50T/200T |
| MB12668 | 1kb DNA Ladder Marker(1000~10000bp) | 100T (2×250μl) |
| MB2509 | Sybr green I(电泳级)核苷酸胶体染料; | 100μL/500μL |

